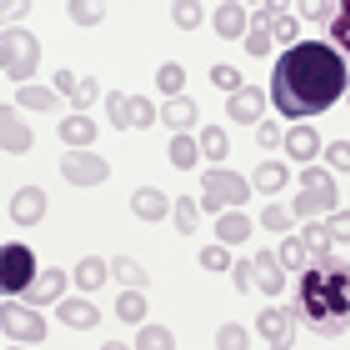

Myeloproliferative Neoplasms
Latest News
Latest Videos

CME Content
More News

The landscape for the diagnosis and treatment of polycythemia vera (PV) is changing, and that's good news for patients and practitioners who can look to improvements ahead.

The telomerase inhibitor imetelstat has shown encouraging signs of clinical activity in patients with myelofibrosis and essential thrombocythemia.

Ruben A. Mesa, MD, deputy director, Mayo Clinic, discusses the intended patient population with myelofibrosis and low platelet counts for pacritinib.

Lead PERSIST-1 author Ruben A. Mesa, MD, deputy director of the Mayo Clinic Cancer Center in Scottsdale, Arizona, discussed the trial's results and pacritinib's potential to change the treatment paradigm for patients with myelofibrosis.

Ruben A. Mesa, MD, deputy director, Mayo Clinic, discusses PERSIST-1, a phase III study which examined pacribitinib as a treatment of myelofibrosis.

Patients with myelofibrosis achieved significantly better outcomes in spleen volume reduction and symptom control with the novel JAK2 inhibitor pacritinib compared with best available therapy.

Pacritinib, a JAK2/FLT3 multikinase inhibitor, significantly reduced spleen volume for patients with myeloproliferative neoplasms when compared to non-JAK2 inhibitors.

For additional insight on the published RESPONSE data and the use of ruxolitnib to treat polycythemia vera, we reached out to Richard Levy, MD, executive vice president and chief drug development and medical officer at Incyte, the company that co-manufactures ruxolitinib with Novartis.




The FDA has approved the JAK1/2 inhibitor ruxolitinib as treatment for patients with polycythemia vera who are resistant or intolerant to hydroxyurea

The FDA has assigned a priority review designation to the JAK1/2 inhibitor ruxolitinib as treatment for patients with polycythemia vera who are resistant or intolerant to hydroxyurea

In the first pivotal phase III study of a Janus-associated kinase (JAK) inhibitor for the treatment of polycythemia vera (PV), ruxolitinib (Jakafi) was superior to best available therapy (BAT) in maintaining control of hematocrit without the need for phlebotomy and in reducing spleen size in patients with an inadequate response to or intolerance of hydroxyurea.

Rami S. Komrokji, MD, clinical director, Hematologic Malignancies, Moffitt Cancer Center, discusses an analysis of pacritinib for the treatment of myelofibrosis.
Ruxolitinib, a JAK1/2 inhibitor, is the first treatment to demonstrate efficacy in a phase III trial for patients with polycythemia vera (PV), a chronic, incurable blood cancer with limited treatment options

Ayalew Tefferi, MD, hematologist, Mayo Clinic, Rochester, Minnesota, discusses the toxicity of imetelstat in patients with myelofibrosis.

Imetelstat, a telomerase inhibitor, has demonstrated significant activity in myelofibrosis, including complete responses.

Updates on new dosing strategies, formulations, and other information on treatments for patients with non-Hodgkin lymphoma, indolent B-cell non-Hodgkin lymphoma, and myelofibrosis.

The strategy of targeting aberrant signaling in the JAK pathway appears promising thus far for SAR302503, an oral agent in development for the treatment of myelofibrosis.

Ruben A. Mesa, MD, Professor of Medicine, Division of Hematology & Medical Oncology, Mayo Clinic, describes three phase II and phase III trials in myelofibrosis.

Richard T. Silver, MD, Professor of Medicine, Director, Leukemia and Myleoproliferative Center, New York Presbyterian-Weill Cornell Medical Center, discusses the use hydroxyurea and interferons in myeloproliferative neoplasms.

Ruben A. Mesa, MD, Professor of Medicine, Division of Hematology & Medical Oncology, Mayo Clinic, discusses the long-term experience from the COMFORT-I and COMFORT-II trials in myelofibrosis.

Patients with the rare form of blood cancer polycythemia vera whose hematocrit levels hover between 45% and 50% have a four-fold higher incidence of thrombotic complications.

Richard T. Silver, MD, Professor of Medicine, Director, Leukemia and Myleoproliferative Center, New York Presbyterian-Weill Cornell Medical Center, discusses the use of interferons in myeloproliferative neoplasms.













































